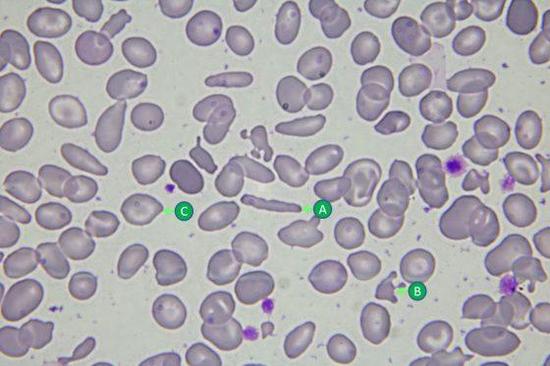

《工作细胞》血管里的微科学故事
红血球其实像颗贝果面包,至于白血球咩,比较像是颗煎坏的荷包蛋……
《工作细胞》里的角色多是可爱的红血球小姐、帅气的白血球先生,和萌萌的血小板萝莉。但在真实的世界里,它们的长相可就不是如此了,红血球通常直径为6~8 μm,长的很像一颗扎实的贝果面包;而白血球稍大,直径为9~12 μm,长的很像……一颗没煎好的荷包蛋。

A:红血球;B:嗜酸性白血球,主要对抗寄生虫;C~ E:嗜中性白血球,主要对抗细菌、病毒,占所有白血球的比例最高;F:血小板。
异常型态红血球。A:镰刀型细胞;B:畸形细胞;C:靶状细胞。
对细菌、病毒和寄生虫而言,人体是个温暖又不乏食物的地方,所以倘若有机会,这些求生存的浪浪微生物就会进入我们温暖的肉体里,与免疫细胞们共同上演一场又一场的生存之战。
大型的入侵者,如阿米巴原虫,会吞食红血球作为食物;小的如疟原虫会钻入红血球体内,不但能直接吸取营养,更可躲避白血球的攻击;而更高招的是那群反转录病毒,把自己的遗传密码直接写入宿主细胞的DNA里,不仅无需担心白血球的攻击,更潜藏于身体里的细胞,几乎无法根除,成了人体的一部份!

上图:吞食红血球的阿米巴原虫;下图:寄生于红血球体内的疟原虫,正处于指环体。from: wikimedia wikimedia
对细菌来说,白血球才是可怕的恶魔!
在这里我要先替细菌说说话,其实以一只小细菌的观点来说,白血球超可怕的啦!仿佛就是《进击的巨人》里的食人巨兽般,利用灵敏的受器“闻”到发炎物质后,会成群结队的奔袭而来。
更可怕的是,一旦发现无助的细菌们,白血球会伸出巨大的伪足加以捕捉、吞噬。可怜的细菌被巨大的白血球吞食之后,还会被白血球体内的过氧化物、酵素等分解成碎片,一命呜呼~而且被撕成碎片的尸体还会被巨噬细胞剪成胜肽片段,送给免疫系统的老大-T细胞进一步刺激免疫反应,以召唤更多的白血球来袭击细菌村庄!想想,以细菌的角度来看,白血球完全不是帅气的型男卫兵,根本就是《沉默的羔羊》里的变态食人魔吧!

上图:化学趋向性/Chemotaxis。细胞表面的受器感受到特定物质的浓度梯度后,会朝向该处前进,或反向该处离开;下图:伸出两只伪足的巨噬细胞。

上图:正在吞噬炭疽杆菌的白血球,比例尺为5 μm;下图:被白血球吞噬后的细菌、病毒或细胞,会和富含过氧化物、酵素的胞器融合为一,最终分解成碎片。
漫画太善良了!真实的世界充满阴谋诡计!
在《工作细胞》的前几话中,出现的敌人都是少量的细菌,白血球们经过一番苦战之后,总是会获得最后的胜利。就算是肿瘤细胞也是仅用两话的时间就清除得干干净净!但免疫系统远比科学家们想像的还要复杂、神奇许多,真实的细胞世界里充满了计谋、背叛和策反之计!
比方说在人类历史上占有一席之地的结核杆菌,是少数能够潜藏在巨噬细胞的细菌,最近更被发现会利用巨噬细胞的讯息传递来提高自己的致病力!而近年来科学家更发现,肿瘤组织会吸引巨噬细胞聚集,让它们释放生长因子,进一步地刺激肿瘤细胞生长、茁壮!如此神奇、工于心计的免疫世界,未来是否也会在《工作细胞》里出现呢?这是多么的令人期待啊!

发表你的评论吧返回顶部
!评论内容需包含中文
